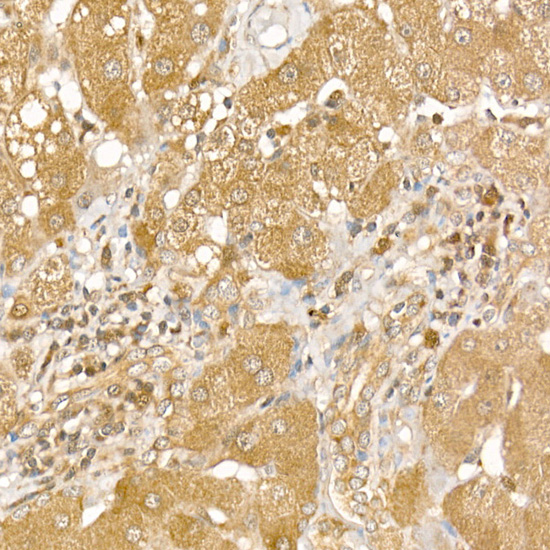

Western Blot analysis of Hela and A431 cell using CSNK1E Polyclonal Antibody at dilution of 1:1550
CSNK1E Polyclonal Antibody
E-AB-10950
Product group Antibodies
Overview
- SupplierElabscience
- Product NameCSNK1E Polyclonal Antibody
- Delivery Days Customer12
- Applications SupplierELISA WB IHC
- CertificationResearch Use Only
- Concentration0.7mg/ml
- Scientific DescriptionThe protein encoded by this gene is a serine/threonine protein kinase and a member of the casein kinase I protein family, whose members have been implicated in the control of cytoplasmic and nuclear processes, including DNA replication and repair. The encoded protein is found in the cytoplasm as a monomer and can phosphorylate a variety of proteins, including itself. This protein has been shown to phosphorylate period, a circadian rhythm protein. Two transcript variants encoding the same protein have been found for this gene.
- UNSPSC12352203